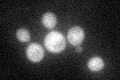
YDL021W
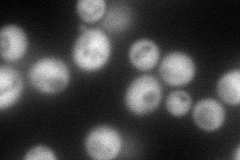
YDL021W
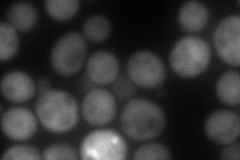
YDL021W
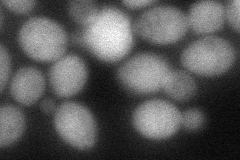
YDL021W
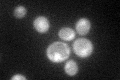
YDL021W

View description
Homolog of Gpm1p phosphoglycerate mutase, which converts 3-phosphoglycerate to 2-phosphoglycerate in glycolysis; may be non-functional derivative of a gene duplication event
Localization:
Intensity:
Fold change:
Significance:
-
C’ GFP library in SD
cytosol34.35 -
N' NOP1pr-GFP in SD
cytosol116.904 -
N' TEF2pr-mCherry in SD
cytosol159.492 -
N' NATIVEpr-GFP in SD

cytosol37.1103 -
N' TEF2pr-VC and Cyto-VN in SD
cytosol59.2045 -
C’ GFP library in SD+DTT

cytosol47.261.37Yes -
C’ GFP library in SD+H2O2

cytosol30.520.88No -
C’ GFP library in Starvation Media
cytosol77.452.25Yes -
C’ GFP library on the background of Pup2-DaMP

cytosol -
C’ GFP library on the background of CCT mutant

cytosol40.09931.16718No
